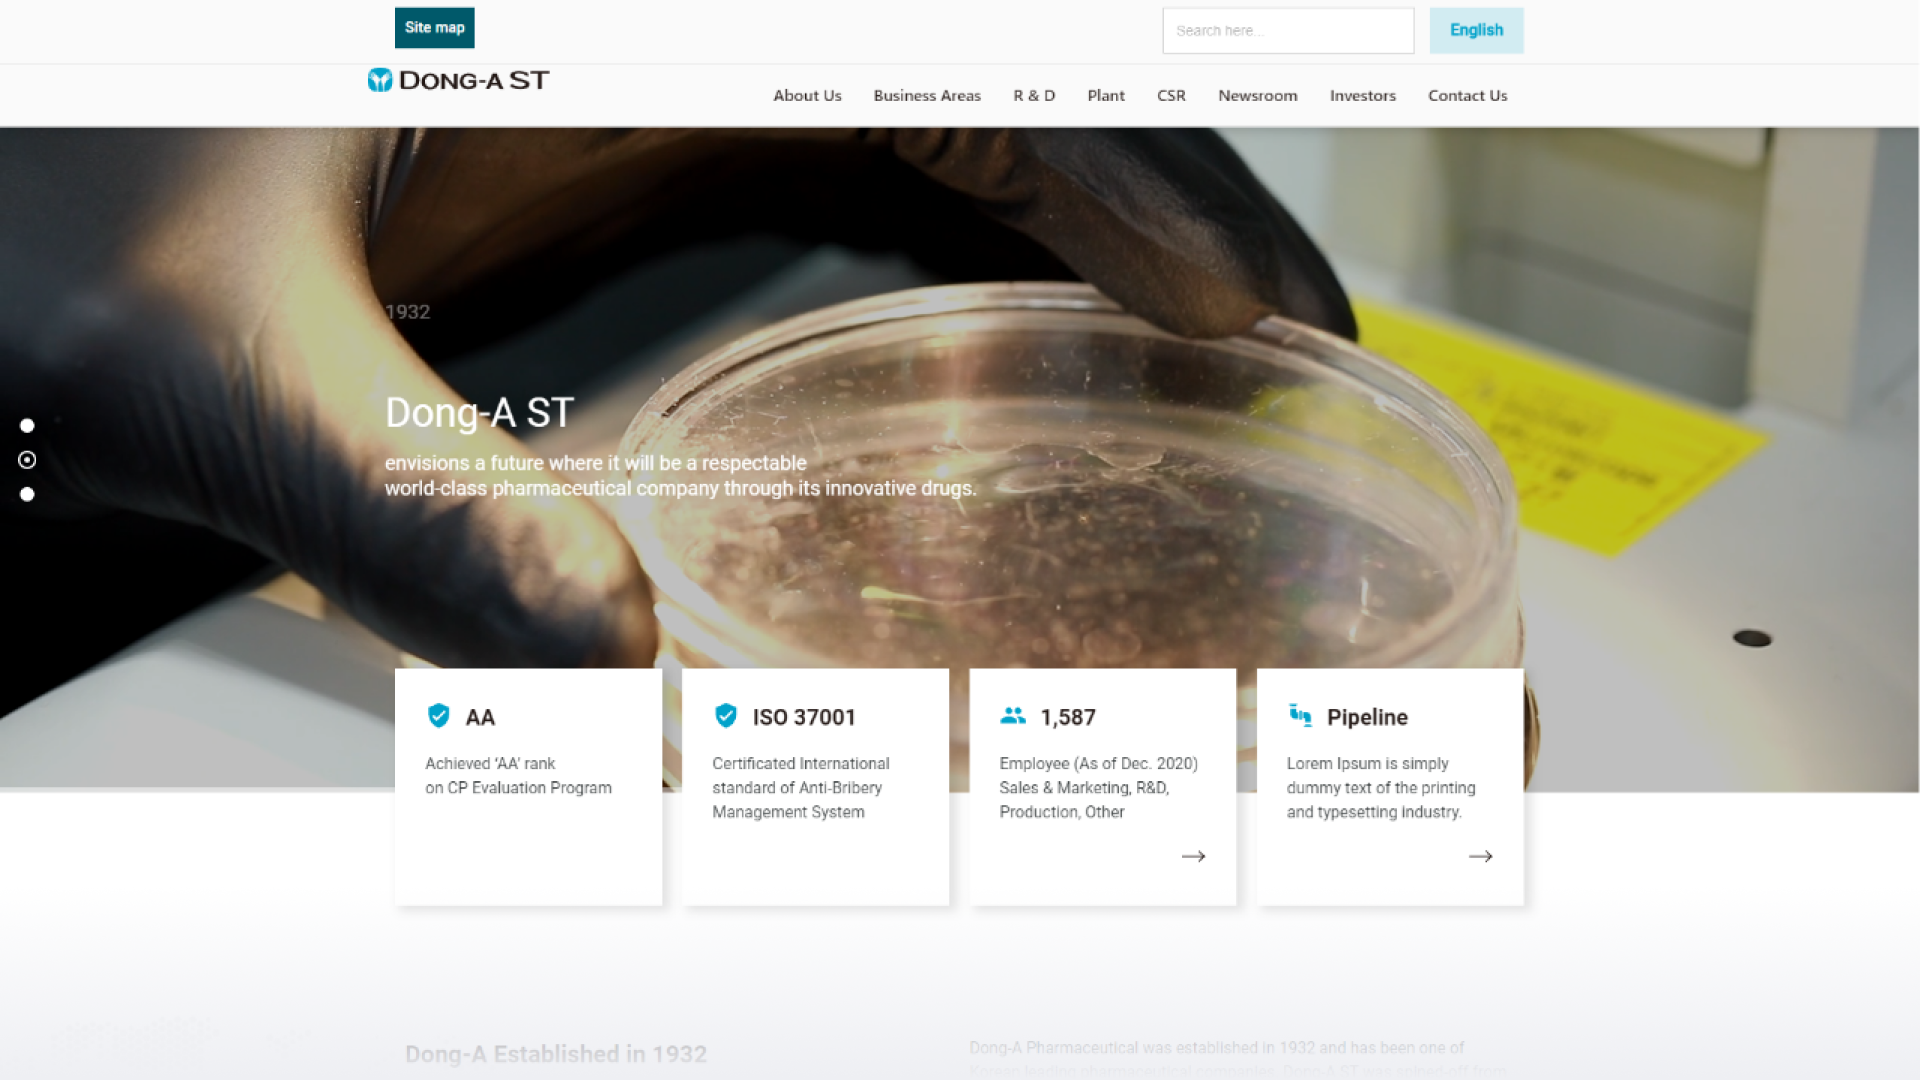
포트폴리오 프로토타입 GIF

동아ST의 최상위 홈페이지 목적은 “브랜드 이미지 재구축” 이었습니다. 기존 동아ST 홈페이지의 경우 템플릿형 UI/UX디자인을 보유하고 있어 트렌디하지 않은 회사 이미지를 홈페이지를 통해 느낄 수 있었습니다. 또한 검색엔진노출에도 안좋은 영향을 미친 사이트맵구조의 개선이 필요한 프로젝트였습니다.
다양한 디바이스와 해상도에 맞춘 반응형 웹을 제작하여 사용자 경험을 제공합니다. 반응형 개발에 맞춰 레이아웃의 구성을 개발 친화적으로 제작하였습니다.
전문적이고 다양한 제품의 정보를 효과적으로 제공하기 위한 서비스로\n 단순히 상품을 구매하는 것 뿐만 아니라 경험하고, 수집하고, 만들어내는 과정을 제공합니다.
깔끔한 내비게이션과 인터페이스 극대화를 통해 사용자 편의성을 증가시켰습니다.

Project
사이트맵 및 동아ST의 규모를 보여주는 카드섹션을 히어로 섹션에 배치시켜 홈페이지 사용성 및 기업가치를 극대화하였습니다.
DONG-A ST



동아ST의 타겟층, 해외 투자사를 위한 기업규모를 보여주는 History, Location등의 자료를 제공하였습니다.
모바일에서도 텍스트 & 사진이 깨지지 않는 반응형 대응 작업을 진행해 PC와 마찬가지로 자연스러운 홈페이지 경험을 선물하였습니다.








가나다
Noto Sans
가나다라마바사아자차카타파하 1234567890
Aa
Noto Sans
ABCDEFGHIJKLMNOPQRSTUVWXYZ abcdefghijklmnopqrstuvwxyz 1234567890
Brand
#26BEE7
Sub
#00596A
Sub
#231815
Bg
#F3F3F3
상담만 받아보셔도 좋습니다 긱다이브의 상담으로 업체 비교를 시작해보세요